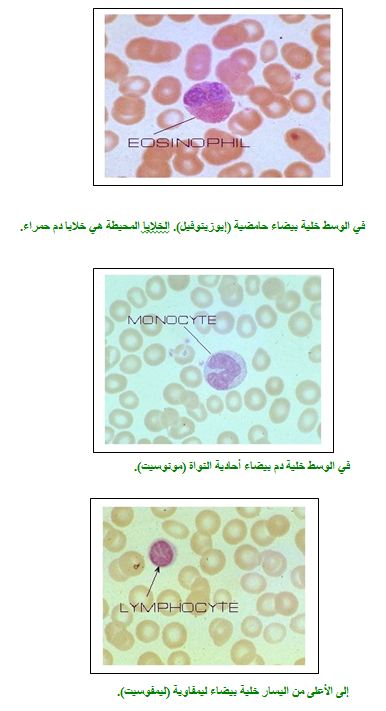

جهاز المناعة
يعتبر علم المناعة علماً حديثاً نسبياً، وتعزى بدايته الى الطبيب الانجليزي إدوارد جينر الذي استطاع أن يطوّر طريقة لحماية الناس من العدوى بمرض الجدري الأسود smallpox) ) قبل أكثر من مئتي سنة (عام 1798 ). والجدري مرض معد يسببه فيروس ينتقل عن طريق المسالك التنفسية ويؤدي الى ندب بشعة في الجلد، غير أن تأثيره القاتل يكمن في اصابته للأعضاء الداخلية. لقد فتك مرض الجدري بالكثير من الناس منذ القدم. وسجل التاريخ المعاناة التي سببها الجدري لسكان اوروبا في القرون الوسطى. انتقل هذا المرض الى امريكا الجنوبية مع المحتلين الإسبان وفتك عام 1553 بمئتي ألف من قبائل الإنكا التي كانت تعيش هناك.
لا شك أن مرض الجدري، مثله مثل أمراض معدية كثيرة ، قد سبب الرعب للبشرية فترة طويلة من الزمن. وعلى مر التاريخ كانت هناك محاولات لمنع انتشار هذا الوباء. ففي الصين القديمة اعتادوا أن يأخذوا القروح الجافة من الاشخاص المصابين بالجدري ويستنشقوها لكي يتقوا الاصابة بالمرض. نجحت هذه الطريقة مع البعض وفشلت مع البعض الاخر. طريقة مشابهة كانت متبعة في تركيا في القرون الوسطى، حيث كانوا يأخذون قليلاً من قروح المصابين بالجدري ويحقنونه في جلد الاشخاص الذين كانوا يرغبون في حماية أنفسهم من الاصابة بالمرض.
في أواخر القرن الثامن عشر، وصل الى علم الطبيب إدوارد جينر أن الفلاحات اللواتي اعتدن على حلب الابقار وأصبن بجدري خفيف الاعراض هو الجدري الذي يصيب البقر(cowpox) لم يمرضن بالجدري القاتل الذي يصيب الانسان. قرر جينر أن يقوم بتجربة لفحص ذلك. إذ أخذ من قروح الأبقار المريضة وحقن بها مجموعة من الأشخاص الأصحاء. راقب جينر هذه المجموعة من الأشخاص، ولاحظ أنهم لم يمرضوا بالجدري على الرغم من الموجات المتلاحقة من العدوى التي ألمّت بالمناطق التي كانوا يسكنونها. تدعى الطريقة التي تهدف الى إكساب الانسان وقاية من المرض " تطعيماً" او "تحصيناً" (vaccination ).عندما قام جينر بتطعيم الناس ضد مرض الجدري لم يكن يعرف يومها شيئاً عن المسببات التي تؤدي الى الأمراض المعدية، بل إن فهم ذلك قد تم في أواخر القرن التاسع عشر بواسطة الأبحاث الرائدة التي قام بها العالم روبرت كوخ. لقد أثبت روبرت كوخ أن الامراض المعدية تسببها كائنات دقيقة (microorganisms ) مختلفة. ونحن نعرف اليوم أربع مجموعات من الكائنات الدقيقة المسببة للأمراض، هي: الفيروسات ، البكتيريا، الفطريات والطفيليات

شكل (1) : بكتيريا كما تظهر في المجهر الإلكتروني.
لقد أدّت اكتشافات روبرت كوخ وسائر علماء المكروبيولوجيا في القرن التاسع عشر وخاصة لويس باستير الفرنسي (الذي نجح في تطعيم الأغنام ضد مرض الجمرة الخبيثة) الى شق الطريق أمام علم جديد هو علم المناعة. وبفضل هذا العلم، تم تطوير طرق تطعيم ناجحة ضد كثير من الامراض المعدية الفتاكة التي طالما أودت بحياة الكثير من الناس مثل الجدري والتهاب غشاء المخ وغيرها.
لقد دأب العلماء منذ أواخر القرن التاسع عشر وحتى يومنا هذا على دراسة الآليات التي يعمل بواسطتها الجسم لحماية نفسه من مسببات الأمراض. ويتوفر الآن قدر هائل من المعرفة في هذا المجال، تم استغلالها للتغلب على كثير من الامراض وما زالت حجر الاساس الذي يعتمد عليه العلماء لمقاومة أمراض لم يتم التغلب عليها حتى الآن مثل السرطان والايدز وغيرها. توجد لدى الكائنات الحية على أنواعها أنظمة مناعية تحميها من مسببات الأمراض. الأنظمة المناعية لدى الحيوانات اللافقارية بسيطة، لكنها متطورة لدى الحيوانات الفقرية وخاصة الطيور والثدييات. ولو تأملنا هذه الأنظمة لدى الانسان لوجدناها تتألف من نوعين رئيسيين: مناعة غير تخصصية ومناعة تخصصية مكتسبة.
ألمناعة غير التخصصية
تتألف هذه المناعة في جسمنا من حواجز فيزيائية وكيماوية ومن خلايا بيضاء لها قدرة ابتلاع مسببات الامراض وتحليلها. فالجلد مثلاً يشكل خط الدفاع الاول، اذ أنه يشكّل حاجزاًً فيزيائياًً لا يسمح بنفاذ مسببات الأمراض الى داخل الجسم. ولو جرح الجلد او احترق، لازدادت نفاذية مسببات الامراض ( بكتيريا، فيروسات, طفيليات...) الى داخل الجسم وعرضته الى الخطر.
عصارات المعدة تشكل حاجزاً كيماوياً وذلك بسبب درجة حموضتها العالية ( PH أقل من 2 ) وبسبب احتوائها على إنزيمات محللة قوية، لذلك فان كثيراًً من مسببات الأمراض لا تنجح بالبقاء في مثل هذه الشروط.
الأهداب والإفرازات المخاطية في المسالك التنفسية مثل الأنف والقصبة الهوائية والشعب الرئوية تعمل باستمرار على إبعاد الأجسام الغريبة ومسببات الأمراض. فالحركة الدائمة للأهداب تقوم بإبعاد الأجسام الغريبة من المسالك التنفسية خارجاًً. أمّا الافرازات المخاطية فانها تقوم بالتقاط هذه الاجسام ومن ثم إبعادها خارجاً بواسطة السعال او العطس.
الافرازات السائلة مثل الدمع والبول تقوم بغسل مسببات الأمراض أو أية اجسام غريبة قد تدخل إليها. فلو انحبس الدمع او قل البول لازداد احتمال إصابة هذه الأعضاء بالتلوث البكتيري أو الفيروسي.
الخلايا البالعة : وهي خلايا بيضاء تنتشر في الدورة الدموية وفي الأنسجة وتقوم بابتلاع وتحليل الأجسام الغريبة.
كل الأمثلة السابقة هي أمثلة على مناعة غير تخصصية أو مناعة عامة، لأن طرق المناعة هذه لا تميّز بين بكتيريا وأخرى أو بين فيروس وآخر، وإنما تقاوم كل مسببات الأمراض بدون أي تخصص.
رغم هذه الحواجز الطبيعية الموروثة فإن مسببات الأمراض تنجح في الدخول الى الجسم. ويتم ذلك من خلال الجروح المفتوحة أو الارتباط بالأنسجة المخاطية ( في المسالك التنفسية، الجنسية والبولية) والتغلغل من خلالها. وعلى سبيل المثال فإن بعض أنواع بكتيريا E.Coli ترتبط بأغشية الخلايا الإبيتيلية في المسالك البولية بحيث لا يتم شطفها مع البول، فتتكاثر وتسبب المرض.
ألمناعة التخصصية المكتسبة
إن الطرق السابقة، وعلى الرغم من أهميتها، غير كافية لحماية الجسم. وقد تطورت، كما ذكرنا سابقاً، عند الفقريات وعلى رأسها الطيور والثدييات طريقة مناعية إضافية هي المناعة التخصصية-المكتسبة. هذه المناعة تخصصية لانها تقاوم كل مسبب مرض بشكل تخصصي وسنتوسع في ذلك لاحقاً. وهذه المناعة مكتسبة لاننا نكتسبها خلال حياتنا من خلال مقاومة مسببات الأمراض المختلفة.
تشترك في تشكيل المناعة التخصصية خلايا مختلفة ( متل خلايا الدم البيضاء، خلايا نخاع العظام...) وأعضاء مختلفة (مثل العقد الليمفاويّة، الطحال...). هذه الشبكة من الخلايا والأعضاء تسمّى معاً "الجهاز المناعي"immune system .

تختلف المناعة التخصصيّة المكتسبة عن المناعة غير التخصّصيّة بما يلي:
يتمّ تفعيل المناعة التخصصيّة فقط بعد دخول الكائنات أو المواد الغريبة الى الجسم ، بينما لا تقوم بأي رد فعل اتجاهها اذا لم تدخل الى الجسم. مثلا ، يقاوم جهاز المناعة فيروس الحصبة فقط إذا دخل الى الجسم.
- هذه المناعة تخصّصيّة. مثلاً ، التطعيم ضد فيروس الحصبة لا يَكسب مناعة ضد فيروس آخر لا يشبهه.
- لهذه المناعة "ذاكرة" أي أنه إذا دخل مسبب مرض الى الجسم مرة ثانية بعد فترة طويلة من الزمن فإن جهاز المناعة "يتعرّف " عليه بسرعة ويقاومه بكفاءة عالية .
إن العمل السليم لجهاز المناعة ضروري لبقاء الكائن الحي. ولعلّ مرض الايدز وهو مرض انهيار المناعة المكتسب أوضح مثال على ذلك. كما أن الاطفال الذين يولدون مع نقص في جهاز المناعة لا يظلّون أحياء إلاّ إذا ربوا في ظروف معقّمة.
يتألف جهاز المناعة من خلايا الدم البيضاء ومن الاعضاء ألليمفوئيديّة.
خلايا الدم البيضاء
تتكوّن خلايا الدم البيضاء من خلايا أصل في نخاع العظام ومن هناك تنتقل الى الدورة الدمويّة. يتراوح عددها في سائل الدم بين 6000 – 10,000 خليّة لكل ملم3 . وهي تتألف من عدة أنواع، وخلال سنوات البحث الطبي تم تصنيفها بموجب معايير مختلفة مثل شكل النواة وطريقة الصبغ والوظيفة وغيرها.
الخلايا البيضاء التي ذكرت تشكّل جزءًا فقط من الخلايا البيضاء الموجودة في جسم الإنسان والتي لها أعظم التأثير في حماية الجسم من الأمراض.
ألاعضاء الليمفوئيدية
هي أعضاء تتميز باحتوائها على أعداد كبيرة جداً من الليمفوسيتات وتحصل فيها عمليات مركزية تتعلق بالمناعة التخصصية.
هنالك نوعان من الاعضاء الليمفوئيدية:
- أعضاء ليمفوئيدية أولية يتم فيها انتاج أو نضوج الليمفوسيتات، مثل نخاع العظام والثيموس. نخاع العظام هو نسيج يوجد داخل العظام وهو المسؤول عن إنتاج خلايا الدم الحمراء والبيضاء وصفائح الدم. أما الثيموس فهو عضو يوجد بين الرئتين ويكون حجمه كبيراً لدى الاطفال إلا أنه يأخذ بالتضاؤل مع التقدم في السن. في الثيموس يحصل نضوج لأحد أنواع الليمفوسيتات التي سميت نسبة اليه بخلايا T .
ب- أعضاء ليمفوئيدية ثانوية تحصل فيها ردود الفعل المناعية وهي تتألف من: العقد الليمفاوية، الحويصلات الليمفاوية، الطحال، اللوزتين وبقع بيير. ألعقد الليمفاوية (lymphatic nodes ) هي أعضاء ذات أغلفة تصل اليها وتخرج منها أوعية ليمفاوية وتوجد في أماكن كثيرة من الجسم (تحت الإبطين، في جانبي العنق، في أعلى الفخذ، بالقرب من أعضاء الجسم الداخلية...).
أما الحويصلات الليمفاوية(lymphatic follicles ) فهي كتل خلايا لا غلاف لها تنتشر في النسيج الإبتيلي للأنف والمسالك التنفسية والجنسية والأمعاء. الطحال هو عضو له وظيفة مهمة جداً في تحليل خلايا الدم الحمراء أو المصابة بالإضافة الى كونه عضواً ليمفوئيدياً ثانوياً.
تعرفنا سابقاً على "اللاعبين" المركزيين في جهاز المناعة التخصصية. ولكن ما هي طبيعة المقاومة التي يقوم بها جهاز المناعة ضد مسببات الأمراض والأجسام الغريبة؟
تحدثنا من قبل أن الليمفوسيتات هي الخلايا البيضاء الفاعلة في المناعة التخصصية. هنالك ثلاثة أنواع من الليمفوسيتات:
- ليمفوسيتات T .
- ليمفوسيتات B .
- الخلايا القاتلة الطبيعية (natural killer cells) وهي ليمفوسيتات ليست T وليستB non T non) B cells ).
معدل عدد الليمفوسيتات هو 2000 خلية تقريباً لكل 1 ملم3 من الدم.
تتكون جميع الليمفوسيتات في نخاع العظام ولا تكون لها في البداية أية قدرة مناعية، غير أنها تمر في عملية نضوج وتمايز في الاعضاء الليمفوئيدية الأولية لتتحول بعدها الى خلايا ذات قدرة مناعية.
ألليمفوسيتات التي تنضج في الثيموس تسمى، كما ذكرنا، خلايا T. أما خلايا B فقد سميت بهذا الاسم نسبة الى البورسا (Bursa ). وهو عضو ليمفوئيدي أولي يوجد في الطيور في نهاية الأمعاء بالقرب من فتحة الشرج. في البورسا تتخصص وتنضج الليمفوسيتات من نوع B .
لا يوجد في الانسان عضو مماثل للبورسا، لكن فيه أنسجة لها نفس المقدرة وهي بقع بيير(Payer ) في الامعاء وكذلك نخاع العظام.
تشكل خلايا T و B معظم الليمفوسيتات، غير أن هناك ليمفوسيتات أخرى تختلف بتركيبها وتدعى non T non B cells أو الخلايا القاتلة الطبيعية. سميت بهذا الاسم لانها تملك القدرة على قتل بعض أنواع الخلايا السرطانية.
ما هو دور خلايا B ؟
تتميز هذه الخلايا بأنها ذات قدرة على إنتاج وإفراز مواد جليكوبروتينية تسمى " أجسام مضادة" (antibodies ) وذلك كرد فعل على دخول مسبب مرض أو مادة غريبة الى الجسم. ترتبط هذه الأحسام المضادة بمسبب المرض أو بالمادة الغريبة وتساهم في تدميره.
تنتشر هذه الأجسام المضادة في سوائل الجسم ( مثل بلازما الدم، السائل بين الخلوي، الإفرازات الخارجية مثل الدمع والعرق والحليب ) ولذلك سمي رد الفعل المناعي هذا برد فعل هومورالي أي رد فعل بواسطة سوائل الجسم.
ما هو دور خلايا T ؟
تتألف خلايا T من ثلاثة أنواع:
- خلايا T مساعدة ( Helper T cells وباختصار TH ). لهذه الخلايا دور بالغ الاهمية في تنشيط عمل خلايا B وخلايا T الاخرى.
- خلايا T مسمّة (cyto-toxic T cells )، وباختصار TC . لهذه الخلايا قدرة على تدمير وقتل الخلايا السرطانية والخلايا المصابة بالفيروس وغيرها.
- خلايا T كابحة، أي أنها تقوم بتنظيم نشاط خلاياT الأخرى (suppressor T cells) وباختصار TS .
مما سبق، يتضح أن هناك نوعاً آخر من المقاومة المناعية يتم بواسطة خلايا وليس بواسطة أجسام مضادة ولذلك سمي برد فعل مناعي خلوي.
تؤدي ردود الفعل المناعية السابقة في معظم الاحيان الى تدمير مسبب المرض والى شفاء الجسم، وتظل في الجهاز المناعي "ذاكرة" لهذا المسبب. فاذا دخل الى الجسم مرة ثانية كانت مقاومته أشد وأسرع مما يمنع الاصابة بالمرض.
إن رد الفعل المناعي الذي يحصل عند دخول مسبب المرض لأول مرة يسمى "رد فعل مناعي أولي، أما رد الفعل المناعي عند دخول المرض مرة ثانية فيسمى "رد فعل ثانوي".
لجهاز المناعة قدرة على التعرف والقيام برد فعل تخصصي تجاه عدد هائل جدا من الأنواع المختلفة من الجزيئات. ولم يجد العلماء حتى الآن مادة لا يستطيع جهاز المناعة أن يقوم برد فعل مناعي ضدها.
كل مادة تحفز جهاز المناعة على القيام برد فعل مناعي تخصصي ضدها تسمى أنتيجن (- antigen )، وباللغة العربية "مولد مضاد". فالمركبات التي تتألف منها البكتيريا والفيروسات وسم الثعبان أو العقرب وغيرها هي أنتيجينات.
جهاز المناعة قادر (عادة) على التمييز بين المركبات الذاتية التى يتألف منها الجسم وبين المركبات غير الذاتية أي غير الموجودة بشكل طبيعي في الجسم (self & non self ). في بعض الحالات، ونتيجة لخلل ما، يقوم جهاز المناعة بردود فعل مناعية ضد مركبات ذاتية. ردود الفعل هذه قد تؤدي الى أمراض بعضها صعب وخطير. تسمى هذه الأمراض "أمراض المناعة الذاتية" (autoimmune diseases )، منها مثلاً بعض أنواع الروماتزم (حمى المفاصل) وسكري الشباب وغيرها.
الأجسام المضادة (antibodies )
ان أحد ردود الفعل المناعية المميزة هي تكوين أجسام مضادة. والخلايا المسؤولة عن تكوين وافراز الاجسام المضادة هي ليمفوسيتات B . فهذه الليمفوسيتات عندما "تتعرف" على الانتيجن وبمساعدة خلايا TH، تبدأ بالانقسامات المتتالية. يتمايز قسم من الليمفوسيتات الناتجة الى خلايا تسمى خلايا بلازما (plasma cells ). هذه الخلايا هي التي تكوّن وتفرز الاجسام المضادة الى بلازما الدم والى سوائل الجسم الاخرى.
الاجسام المضادة هي جليكوبروتينات تنتمي الى فئة البروتينات المسماة جلوبولينات. ولان الاجسام المضادة تقوم بوظائف مناعية فقد سميت إمونوجلوبولينات (Immune-globulins ) وباختصار Ig .
هنالك عدة فئات من الامونوجلوبولينات تختلف بتركيبها الكيماوي، تركيزها في البلازما، مكان تأثيرها ووظائفها. هذه الفئات من الامونوجلوبولينات تدعى: IgD, IgE, IgA, IgG, IgM وأكثرها تركيزاً في بلازما الدم هي IgG .
- مواد جليكوبروتينية هي مواد متحدة كيماوياً مع مجموعات سكّر.
مساهمة الامونوجلوبولينات في التخلص من الانتيجين
ذكرنا سابقاً أن تكوين الاجسام المضادة هو أحد ردود الفعل المناعية المهمة وخاصة ضد الانتيجينات الذائبة ( أي غير الخلوية). فكيف تساهم هذه الاجسام المضادة في التخلص من الانتيجين؟
هنالك عدة طرق لتاثير الاجسام المضادة:
- توجد للماكروفاجات مستقبلات تربط الاجسام المضادة من نوع IgG . وعندما ترتبط هذه الاجسام المضادة بالانتيجين فانها تحفز الماكروفاجات على ابتلاعها. وقد اتضح أنه بوجود الاجسام المضادة، فان قدرة الماكروفاجات على ابتلاع وتحليل الانتيجين تزيد بقدر 10 أضعاف.
- الــ complex الناتج من ارتباط الاجسام المضادة ( وعلى الاخص IgM ويليه IgG ) مع الأنتيجين يؤدي الى تفعيل سلسلة من الانزيمات المحللة الموجودة في بلازما الدم والتي تسمى النظام المكمل (complement system )، فتقوم هذه الانزيمات بتحليل الانتيجين. في بعض الاحيان تترسب الانتيجينات المرتبطة بالاجسام المضادة في انسجة الجسم، وبسبب تفعيل انزيمات النظام المكمل يحصل ضرر لهذه الانسجة. وعلى سبيل المثال، تؤدي هذه الظاهرة احياناً الى اصابة انسجة الكلية مما يؤدي الى انخفاض قدرتها على العمل. وقد يكون الضرر صعباً لدرجة تتوقف بسببه الكلية عن العمل، تسمى هذه الظاهرة"الفشل الكلوي" .مثال آخر يحصل بسبب تفعيل النظام المكمل هو نقل أجسام مضادة من نوع anti-Rh الى شخص يحمل فصيلة دم Rh+ . ترتبط هذه الاجسام المضادة بخلايا الدم الحمراء وتؤدي الى تفعيل الانزيمات المحللة على سطح الخلايا الحمراء مما يسبب انحلالها (haemolysis ).
- طريقة أخرى تساهم بواسطتها الاجسام المضادة في حماية الجسم هي أن ارتباطها بالانتيجين قد يؤدي الى ابطال فعاليته. مثلاً، ارتباط الاجسام المضادة بمادة سامة دخلت الى الجسم قد يبطل مفعول هذه المادة ويمنع تأثيرها على الجسم، أو ارتباط الاجسام المضادة بفيروس قد يمنع دخوله الى الخلايا.
خلايا B تحتاج الى تعاون خلاياT والماكروفاجات لكي تعمل
على الرغم من وجود بعض الانتيجينات التي تستطيع تفعيل خلايا B مباشرة وتحفيزها على التمايز الى خلايا بلازما وإفراز أجسام مضادة، إلا أن معظم ردود الفعل المناعية التي تقوم بها خلايا B لا تتم إلا بمعاونة خلايا T والماكروفاجات. الماكروفاجات هي خلايا دم بيضاء بالعة كبيرة نسبياً ( 25-50 ميكرون )، مصدرها من الخلايا احادية النواة ( المونوسيتات monocytes ) الموجودة في بلازما الدم. وهذه الخلايا حين تترك الدورة الدموية وتستوطن بين الخلايا في الانسجة تتمايز الى ماكرفاجات. تتصف الماكروفاجات بمبناها المسطّح وقدرتها على الإلتصاق كما أنها أكبر حجماً من المونوسيتات.
تقوم الماكرفاجات بدور مساعد مهّم في رد الفعل المناعي التخصصي. أظهرت التجارب أنه عند دخول أنتيجين معيّن الى الجسم، فإن الماكروفاجات تقوم بابتلاعه ثمّ تفكيكه الى أجزاء صغيرة ثمّ ترتبط هذه المركبات داخل عضّي خاص في الماكروفاج ببروتين يدعى MHC2 . بعد ذلك ينتقل المركب الناتج من ارتباط الانتيجين مع ال MHC2 الى الغشاء أي يعرض على الغشاء. تستطيع خلايا THالمناسبة أن ترتبط بهذا المركب فيتم تفعيلها وبذلك تحفز خلايا B على الإنقسام والتمايز الى خلايا بلازما. بدون هذه العملية، لا تستطيع خلايا TH أن تقوم بدورها في رد الفعل المناعي.
خلايا TH المفعلة تقوم بافراز بروتينات تدعى انترلوكينات لها أكبر الأثر في انقسام خلايا B وتمايزها إلى خلايا بلازما مفرزة للأجسام المضادة، ومن أهم هذه الإنترلوكينات IL-2 و IL-4 و IL-6 .
طريقة تأثير خلايا TC
ذكرنا سابقاً أن خلايا B تتعرف على الأنتيجين بكامله دون أن تتم معالجته أو عرضه بواسطة الماكروفاجات أو أي خلايا أخرى. أما خلايا TH فلا تتعرف على الأنتيجين إلا بعد معالجته بواسطة الماكروفاجات وعرضه على الغشاء سوية مع جزيئات MHC2 . الأجسام المضادة التي تكوّنها خلايا البلازما غير فعالة بما فيه الكفاية في تدمير الخلايا الغريبة مثل الخلايا السرطانية أو الخلايا المصابة بالفيروس. فالأجسام المضادة غير قادرة على المرور عبر أغشية الخلايا بسبب جزيئاتها الكبيرة نسبياً وبالتالي فهي لاتستطيع الوصول الى الفيروس الذي يتكاثر داخل الخلية. مقاومة هذه الخلايا الغريبة يتمّ في الأساس بواسطة الليمفوسيتات من نوع TC .
كيف تميّز هذه الخلايا بين الخلايا الغريبة وبين الخلايا الإعتيادية؟
إحدى التجارب التي أجابت على هذا السؤال أجريت عام 1974 . في هذا التجربة اخذوا فأراً من نوع A بعد أن حصّن بفيروس LCM بهدف انتاج خلايا TC تخصصية ضد هذا الفيروس. بعد ذلك أخذت خلايا طحال من هذا الفأر المحصّن ضد LCM وقسّمت الى ثلاث مجموعات:
- مجموعة أضيفت الى خلايا فأر من نوع A بعد ان أعديت بفيروس LCM .
- مجموعة أضيفت الى خلايا فار من نوع A بعد أن أعديت بفيروس آخر.
- مجموعة أضيفت الى خلايا فأر من نوع B بعد أن أعديت بفيروس LCM .
كانت النتيجة أنّ خلايا الفار من نوع A التي أعديت بفيروس LCM قد تمّ تدميرها ( كما هو متوقع ) وأنّ خلايا الفار من نوع A التي أعديت بفيروس آخر لم يحصل لها أي ضرر ( كما هو متوقع )، لكن المفاجأة كانت بأن الخلايا التي أخذت من نوع آخر من الفئران وعلى الرغم من أنها أعديت بنفس الفيروس، إلا أنها لم تتأثر ولم تدمّر. أي أن خلاياTC تتعرف على مادة ذاتية معينة وعلى مادة تابعة للفيروس معاً ولا تتعرف على أي منهما بانفراد. اتضح فيما بعد أنّ هذه المادة الذاتية عبارة عن بروتين يدعى MHC1 . أي أنّ الأنتيجين الفيروسي يجب أن يعرض على أغشية الخلايا سوية مع ال MHC1 حتى تستطيع خلايا TC التعرف عليه. ويمكننا معرفة أهميةال MHC1 من الحقيقة بأنّ الخلايا السرطانية التي لا تكوّن هذه المادة تستطيع أن " تتهرب " من الجهاز المناعي وبذلك تتكاثر في الجسم دون أن تقاومها خلايا T .
إنّ مركب ال MHC1 يوجد تقريباً في كل خلايا الجسم، وبذلك فإن كل خلية من الممكن أن تكون خلية هدف ل TC فيما لو أعديت بفيروس أو تحولت إلى خلية سرطانية. أمّا مركب ال MHC2 فيوجد فقط في الخلايا التي تعالج وتعرض الأنتيجينات مثل الماكروفاجات والخلايا الدندريتية وخلايا B . وفي الحالتين تعمل جزيئات ال MHC كناقلات لتوصيل المحددات الأنتيجينية الى غشاء الخلية، لأنه من دون ذلك لن تستطيع ليمفوسيتات T من التعرف على هذه المحددات الأنتيجينية وإثارة رد الفعل المناعي ضدها.
إن خلايا TC ترتبط مع خلايا الهدف بحيث أن مستقبلاتها ترتبط مع المحددات الأنتيجينية المعروضة سوية مع جزيئات MHC1 . عندها تفرز خلية TC الى داخل خلية الهدف مواد سامة، قسم منها يفعّل سلسلة من العمليات التي تؤدي الى موت مبرمج للخلية (Apoptosis ) يحصل فيه تقطيع لل DNA ، والقسم الآخر من المواد السامة يؤدي الى تكوين ثقوب في غشاء خلية الهدف ودخول الماء الى الخلية ومن ثم انفجارها.
ألطريقة الأولى، أي الموت المبرمج للخلية، هي أكثر فعالية وأهمية. لأنه بهذه الطريقة يتم تقطيع ال DNA بما في ذلك ال DNA التابع للفيروس وبالتالي وقف انتشار الفيروس في الجسم.
التطعيم الفعّال
إنّ التطعيم الذي ابتدأه الطبيب الإنجليزي إدوارد جينر في القرن الثامن عشر ضد الجدري قد مهّد الطريق للوقاية من أمراض عديدة وفتاكة مثل : السل، الدفتيريا، الطاعون، شلل الاطفال، الحصبة وغيرها. لا شك أن التطعيم يحصل ايضاً بشكل طبيعي. فمن مرض بالحصبة وهو صغير يكتسب مناعة مدى الحياة ولا يمرض ثانية. غير أننا لا نستطيع الإعتماد على التطعيم الطبيعي، فبعض الأمراض خطير وفتاك ويسبب نسبة مرتفعة من الوفيات بين الاطفال. لذلك فإن أحد الحلول المثلى للوقاية من الأمراض هو تطعيم الأطفال منذ السنة الأولى لحياتهم، ويتمّ ذلك بواسطة حقنهم بمسبب المرض بشرط أن يكون هذا المسبب ميّتاً أو مضعّفاً. تتم معالجة مسبب المرض بواسطة مواد كيماوية ( فورمألدهيد مثلاً ) أو بواسطة الحرارة. إن التغيير المرجو في مبنى مسبّب المرض يجب ألا يكون كبيراً، لأنه عندئذ تفقد الذاكرة المناعية فعاليتها ضد مسبب المرض الحقيقي. من ناحية أخرى، فإن استعمال مسببات أمراض ( خاصة فيروسات ) ضعيفة ولكنها غير ميتة قد يشكل خطراً على الحياة، إذ قد يتحول هذا الفيروس الضعيف الى فيروس عنيف ويسبّب عكس ما كنا نرجوه، أي المرض الذي حاولنا أن نحمي الجسم منه.
يحاول الباحثون اليوم ايجاد لقاحات تطعيم لا تشكل خطورة على حياة الناس. منها مثلاً أن يكون لقاح التطعيم مؤلفاً من بروتينات غلاف الفيروس فقط بدون مادته الوراثية وبذلك يمنع تكاثره في الجسم. هذه الطريقة، وإن كانت آمنة، غير ناجعة تماماً. فالتطعيم بواسطة بروتينات الغلاف فقط يحفّز في الأساس نشوء ذاكرة مناعية هومورالية-أي مسؤولة عن تكوين أجسام مضادة. ونحن نعرف أنّ الأجسام المضادة غير فعالة تماماً في القضاء على الفيروسات. فالفيروس الذي " يختبئ " ويتكاثر داخل الخلايا محمي من الأجسام المضادة التي لا تستطيع اختراق أغشية الخلايا والوصول اليه. رد الفعل المناعي الخلوي هو الأكثر نجاعة في مقاومة الفيروسات، لأنه يقضي على الخلايا المصابة بالفيروس. وتلعب خلايا TC دوراً هاماً في هذه المقاومة كما أسلفنا سابقاً.
للحصول على ذاكرة مناعية خلوية ( خلايا ذاكرة من نوع TC ) يجب أن يكون لقاح التطعيم مؤلفاً من فيروسات كاملة وليس من بروتينات أغلفتها فقط. وقد جاء تطور الهندسة الوراثية في الآونة الأخيرة ليعطي بعض الإجابات لحل هذه المشكلة. إذ يمكن " هندسة " الفيروسات وراثياً بحيث تظل قادرة على دخول الخلايا ولكنها لا تسبب الضرر لها. ألتطعيم بفيروسات كهذه من شأنه أن ينشئ ذاكرة مناعية ناجعة ضد الفيروس الحقيقي وفي نفس الوقت لا يشكل أي تهديد للجسم.
التطعيم غير الفعّال أو السالب
هذا النوع من التطعيم يعتمد على حقن المصاب بمصل يحتوي على أجسام مضادة جاهزة ضد مسبّب المرض. من الواضح أننا لا نستطيع استعمال هذه الطريقة للوقاية من الأمراض، فالأجسام المضادة لا تظل فترة طويلة في الجسم بل تتحلل وتفقد فعاليتها. ونحن بهذه الطريقة لا نحفّز جهاز المناعة على القيام برد فعل لأننا لا ندخل الأنتيجين الى الجسم، وبالتالي لا تتكوّن ذاكرة مناعية.
نستعمل هذه الطريقة من التطعيم فقط بعد الإصابة وذلك لكي نمنع تطور المرض في الجسم. وعلى سبيل المثال، إذا تعرض أحد الأشخاص لعضّة كلب ولم يكن مطعّماً ضد داء الكَلَب من قبل، يجب حقنه بأجسام مضادة جاهزة ضد الفيروس الذي يسبب هذا المرض. فهذه الأجسام المضادة ترتبط بالفيروس وتمنع دخوله الى الخلايا، وبذلك تحمي هذا الشخص من الإصابة بهذا المرض الخطير. التطعيم الفعّال بعد الإصابة غير ناجح: أولاً لأن مسبب المرض الحقيقي يكون قد دخل الى الجسم وهونفسه الذي يحفّز جهاز المناعة، وثانياً لأن المرض يشتد قبل أن يحصل رد الفعل المناعي الاولي والذي يبدأ كما نعرف بعد أسبوعين على الأقل من التعرض لمسبب المرض.
التطعيم السالب مستعمل أيضاً لمقاومة سم الثعابين والعقارب وغيرها. إذ توجد في المراكز الطبية أمصال تحتوي على أجسام مضادة ضد مختلف أنواع السموم، ومن المفضل معرفة نوع الثعبان أو العقرب الذي لدغ، لكي يتسنى للأطباء اعطاء المصل المناسب.
لقد بدأ استعمال التطعيم السالب منذ القرن التاسع عشر، حيث كانوا يحقنون حيوانات كبيرة مثل الخيل بمسببات الامراض ثمّ يأخذون عيّنات من دمائها ويفصلون خلايا الدم منها ويستعملون المصل المتبقي لمعالجة الأمراض. لقد كان استعمال هذه الطريقة كثير المشاكل بسبب ما تؤديه من ردود فعل مناعية جانبية قد تكون أحياناً أصعب من المرض. أما اليوم فيتم الحصول على الأجسام المضادة بشكل نقي وتستحضر بشكل خاص في مستنبتات خلايا.
 الاكثر قراءة في المناعة
الاكثر قراءة في المناعة
 اخر الاخبار
اخر الاخبار
اخبار العتبة العباسية المقدسة


